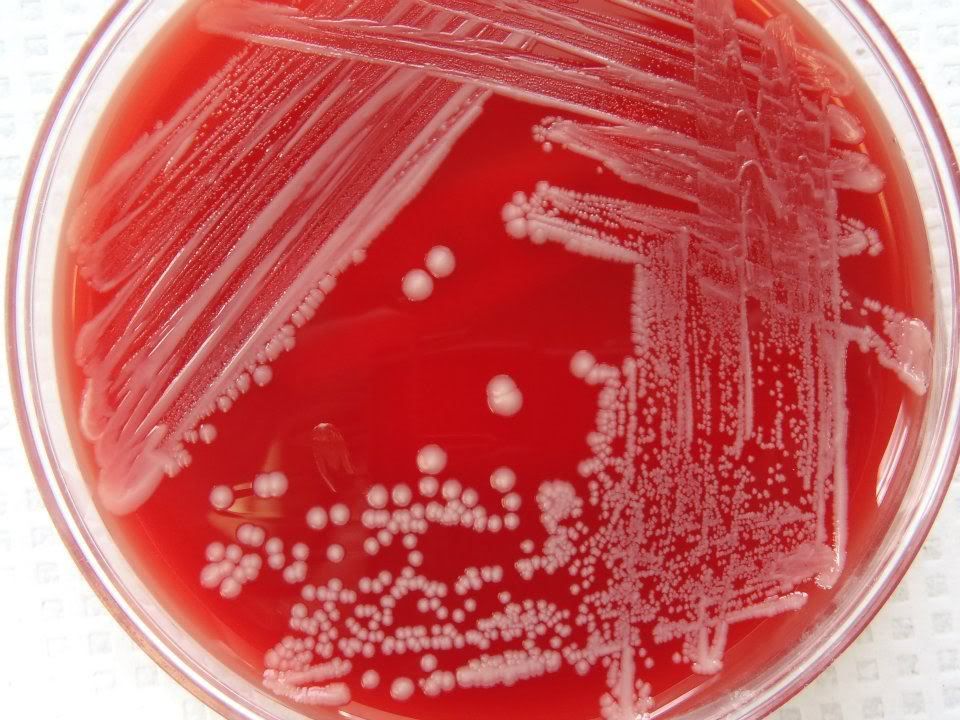
Moraxella Catarrhalis Pictures, Images & Photos Photobucket

Moraxella (benannt nach Victor Morax) ist eine Gattung aerober gramnegativer Bakterien.
Die Gattung Moraxella wird heute der Familie Moraxellaceae (Ordnung Pseudomonadales) zugeordnet, nachdem man sie früher der Familie Neisseriaceae zugeordnet hatte. Es handelt sich um Kokken, Diplokokken oder kurze Stäbchen, die auf Blutagar kleine Kolonien bilden und oxidasepositiv sind. Flagellen sind nicht vorhanden, allerdings können sich einige Arten durch die sogenannte twitching motility oder Zuckbewegung, fortbewegen. Die Bewegung erfolgt hierbei sprunghaft und wird durch spezielle Pili ausgelöst. Mehrere Arten gehören zu der Gattung, darunter die in der Mundflora und im Oropharynx des Menschen vorkommende Kokkenart Moraxella catarrhalis, welche neben Infektionen der Atemwege (mit Otitis, Sinusitis, Bronchitis und Pneumonie) auch Infektexazerbationen der chronisch-obstruktiven Lungenerkrankung (COPD) hervorrufen kann, und Moraxella bovis, die Ansteckende Hornhaut- und Bindehautentzündung der Rinder verursachen kann, sowie Moraxella osloensis, die als biologisches Mittel gegen Wegschnecken diskutiert wird, obwohl sie gelegentlich auch humanpathogen sein kann. Zur Behandlung kommen Cephalosporine, Chinolon-Antibiotika oder Tetracycline in Frage, da sich gegenüber Penicillin eine Resistenz entwickelt hat (Moraxella catarrhalis ist häufig Beta-Laktamase-positiv und somit resistent gegen Ampicillin).
Arten
Eine Liste der vorhandenen Arten:
- Moraxella atlantae Bøvre et al. 1976
- Moraxella boevrei Kodjo et al. 1997
- Moraxella bovis (Hauduroy et al. 1937) Murray 1948
- Moraxella bovoculi Angelos et al. 2007
- Moraxella canis Jannes et al. 1993
- Moraxella caprae Kodjo et al. 1995
- Moraxella catarrhalis Frosch and Kolle 1896
- Moraxella cuniculi (Berger 1962) Bøvre and Hagen 1984
- Moraxella equi Hughes and Pugh 1970
- Moraxella lacunata (Eyre 1900) Lwoff 1939
- Moraxella lincolnii Vandamme et al. 1993
- Moraxella nonliquefaciens (Scarlett 1916) Lwoff 1939
- Moraxella oblonga Xie and Yokota 2005
- Moraxella osloensis Bøvre and Henriksen 1967
- Moraxella pluranimalium Vela et al. 2009
- Moraxella porci Vela et al. 2010
- Moraxella saccharolytica Flamm 1956
- Moraxella urethralis Lautrop et al. 1970
Literatur
- Die Aktivierung des humanen Bronchialepithels durch Moraxella catarrhalis Dissertation von Carola Jonatat.
- Tamang MD, Dey S, Makaju RK, Jha BK, Shivananda PG, Bhramadatan KN: Prevalence of Moraxella catarrhalis infections of the lower respiratory tract in elderly patients. In: Kathmandu Univ Med J (KUMJ). 3. Jahrgang, Nr. 1, 2005, S. 39–44, PMID 16401943.
- Powe TA, Nusbaum KE, Hoover TR, Rossmanith SR, Smith PC: Prevalence of nonclinical Moraxella bovis infections in bulls as determined by ocular culture and serum antibody titer. In: J. Vet. Diagn. Invest. 4. Jahrgang, Nr. 1, Januar 1992, S. 78–9, PMID 1554773.
- Walls A, Wald E: Neonatal Moraxella osloensis ophthalmia. In: Emerging Infect. Dis. 11. Jahrgang, Nr. 11, November 2005, S. 1803–4, PMID 16422012 (cdc.gov [PDF]).
- Marianne Abele-Horn: Antimikrobielle Therapie. Entscheidungshilfen zur Behandlung und Prophylaxe von Infektionskrankheiten. Unter Mitarbeit von Werner Heinz, Hartwig Klinker, Johann Schurz und August Stich, 2., überarbeitete und erweiterte Auflage. Peter Wiehl, Marburg 2009, ISBN 978-3-927219-14-4, S. 265.
Einzelnachweise
Weblinks
![]()